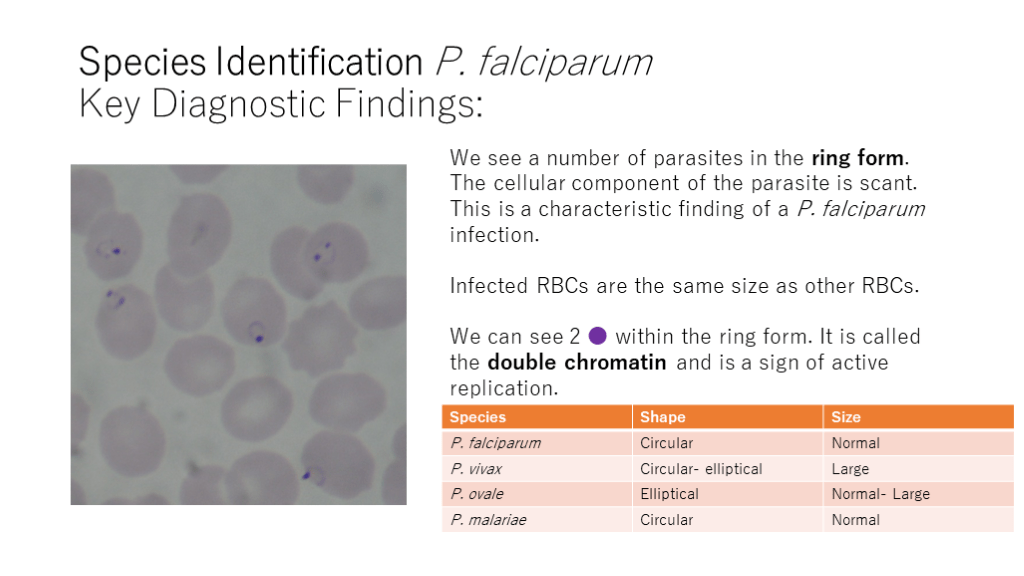

1/60
関連するスライド
「Q&A付き」 " やってみよう!戦略的抗菌薬選択 "
山口裕崇
46456
125
入院患者の発熱の語呂合わせ
関川喜之
19022
146
初期研修医向けグラム陰性桿菌の基本
関川喜之
2918
23
麻疹について最低限・大人のワクチン接種など
nk
17653
68
Microscopic identification of Malaria
2,255
9
概要
Microscopic identification of Malaria
本スライドの対象者
専攻医/専門医
投稿された先生へ質問や勉強になったポイントをコメントしてみましょう!
0 件のコメント
森博威さんの他の投稿スライド
このスライドと同じ診療科のスライド
テキスト全文
マラリアの顕微鏡診断の概要と導入
#1.
Microscopic identificationof Malaria Hirotake Mori Department of General Medicine, Juntendo University Faculty of Tropical Medicine, Mahidol University h.mori.oa@juntendo.ac.jp マヒドン大学熱帯医学短期研修 http://mahidoltropicalmedicine.com/ Faculty of Tropical Medicine, Mahidol University https://www.tm.mahidol.ac.th/eng/index-eng.php
#2.
Introduction This presentation explores the microscopic characteristics of the malaria parasite. Diagnosis can be challenging for the untrained eye, but there are strategies that can help with the process. WHO Guidelines for the Treatment for Malaria was used as the reference material. For further information, please visit: http://apps.who.int/iris/bitstream/10665/162441/1/9789241549127_eng.pdf
診断前の考慮事項と治療法
#3.
Considerations before Diagnosis ① Severe malaria always requires intravenous treatment regardless of the species of malaria. Please refer to the WHO guidelines for the definition of severe malaria. Even if the species cannot be identified, begin IV treatment immediately if the criteria for severe malaria is met. It is crucial to start the treatment as soon as possible.
#4.
Considerations before Diagnosis ② The possibility of co-infection Both P. falciparum and P .vivax species are known to inhabit Thailand. Co-infection of the two species is often identified. An investigation conducted by Mahidol University revealed that even the most experienced clinicians can miss co-infections. In particular, the detection of P. falciparum remains a challenge as the organism evades detection by intravascular sequestration during the growing trophozoite stage and beyond. It is important not to rely solely on microscopy for the diagnosis. Misdiagnosis / missed diagnosis still occur in experienced countries like Thailand that face many cases per year.
#5.
Considerations before Diagnosis ③ Rapid Diagnostic Testing (RDT) is effective In the case of low parasitic load, diagnosis by microscopic evaluation may be challenging. Although RDT vary in sensitivity and specificity, it is generally thought to be around 90% and 90%, respectively. In the case of P. falciparum, test results may be positive even without apparent infection according to the blood smear. Antigens pHRP2 and pLDH are utilized in these kits. pLDH can be used to test for P. falciparum and other co-infections. Keep in mind that a patient with a recent infection may still test positive. However, RDT remains a valid choice because the patient will become negative within 1 month after convalescence.
マラリアの血液塗抹標本とその構造
#6.
Blood Smears Two types of smears, thick and thin smears are used for diagnosis. It is recommended to examine both smears if possible. A thick smear examines a thick sample of hemolyzed RBCs. It is evaluated solely for presence of malaria parasites. A thin smear examines intact RBCs. It is evaluated for the presence of parasites within the RBC and condition of the infected RBCs. Although thick smear examinations have a higher sensitivity, it is a challenging method for those without ample experience. Thin smear evaluations are therefore recommended for the inexperienced clinician. It is important to examine multiple specimens to prevent misdiagnosis / missed diagnosis.
#7.
What is Malaria (Plasmodium)? Plasmodium spp. is a unicellular parasite. It is dependent on the Anopheles mosquito for reproduction and spread. It is part of the Apicomplexa, Coccidia genus. It is structurally similar to Toxoplasma, Cryptosporidium spp. It requires a host for its oxygen supply. The definitive host is the mosquito where it undergoes sexual reproduction. Humans are the intermediate host where it undergoes asexual reproduction. Currently, 5 species of malaria are known to infect humans: ①P. falciparum ② P. vivax ③ P. malariae ④ P. ovale ⑤ P. knowlesi
#8.
Currently, 5 species of malaria are known to infect humans: 1)P. falciparum 2)P. vivax (classically known as Tertian Fever) 3)P. malariae (classically known as Quartan Fever) 4)P. ovale 5)P. knowlesi 1) ~ 4) → human-human route 5) → human-human, primate-human route (zoonotic infection) What is Malaria (Plasmodium)?
#9.
Lifecyle of Malaria The mosquito blood meal transmits the parasite into the bloodstream. After reaching the liver, it develops into the liver schizont. Upon maturation, it ruptures and releases merozoites into the bloodstream where they infect RBCs. Human Blood Stage: Ring form(Early Trophozoite) →Growing Trophozoite →Late Trophozoite →Schizont (maturity) The schizont ruptures and releases merozoites into the bloodstream. These new merozoites will continue to infect other RBCs.
#10.
The Basic Structure of Malaria: Trophozoite RBC RBC infected with malaria: ● Chromatin: nucleus of the parasite; semilunar shape →Cytoplasm: cellular component of the parasite Empty portion → Vacuole with fluid retention Dots are found within the RBC but external to the parasite.
トロフォゾイト段階の特徴と識別
#11.
Trophozoite Stage Early trophozoite (Ring form) sparse cellular component large vacuole ring-shaped formation Late trophozoite cellular component takes up the majority of the RBC vacuole further decreases in size Growing trophozoite increasing density of the cellular component vacuole decreases in size
#12.
The Basic Structure of Malaria: Trophozoite RBC RBC infected with malaria: ● Chromatin: nucleus of the parasite; semilunar shape →Cytoplasm: cellular component of the parasite Empty portion → Vacuole with fluid retention Dots are found within the RBC but external to the parasite.
#13.
Ring Form(Early Trophozoite) The early trophozoite stage is seen within the infected RBC. It is also also known as the ring form due to its characteristic shape. The ring-shaped component is its cytoplasm. ● is the chromatin (nucleus). Take note of the sparse cellular component. The vacuole with fluid retention is seen as the central transparent region.
#14.
Growing Trophozoite The cellular component of the parasite increases in size while the vacuole decreases in size. This is characteristic of the growing trophozoite. This stage plays an essential role in identifying the species of malaria as there are many visual differences among the species. In the late trophozoite, the cellular component continues to grow in size, while the vacuole significantly decreases in size.
#15.
Late Trophozoite The cellular component continues to grow in size, while the vacuole significantly decreases in size. In the late trophozoite stage, the parasite takes up a large portion of the RBC.
シュゾント段階とその重要性
#16.
Schizont (Mature schizont) After trophozoite maturation and the disappearance of the vacuole, the parasite enters the schizont stage. At this stage, the parasite is ready to begin replication. Replicated bodies are called merozoites. Early schizonts are identified by 2 replicated bodies. Mature schizonts have completed replication and harbor a number of replicated bodies. The central portion is called the growing schizont. After completing replication, the membrane of the RBC is ruptured, releasing the merozoites into the bloodstream. The merozoite count is specific to the species of malaria. 10 merozoites can be seen in the image on the right.
#17.
Species Identification① Merozoite Count The merozoite count is a key factor in identifying the species of malaria. If the merozoite count is over 16, we can exclude P. ovale and P. malariae.
#18.
Species Identification ② The Shape of the Infected RBC Take note of the shape of the following specimen: From the oval (egg) shape of the infected RBC, P. ovale can be identified. A relatively dense parasitic cellular component is also seen; this is the growing trophozoite stage.
#19.
Species Identification ② The Size of the Infected RBC Compare the sizes of the following specimens: These infected cells are the same size as the surrounding RBCs. On the left: P. falciparum On the right: P. malariae
#20.
Species Identification② The Size of the Infected RBC Take note of the size of the following specimen: It is larger than the surrounding RBCs. It is important to note that RBCs do not grow in size upon infection. Rather, certain species have a predilection to infect immature RBCs which are larger than mature RBCs. This is an infection caused by P. Vivax.
マラリアの種識別における特徴
#21.
Species Identification② The Size of the Infected RBC If the size of the infected RBC is normal, identification should be based on the growing trophozoite, late trophozoite, and the schizont stages; it may be difficult to identify the species from the ring form.
#22.
Species Identification ③ Dots Dots can be seen within infected RBCs and occupy the space external to the parasite.
#23.
Species Identification ③ Dots Are dots visible in the following specimen? This is an infection caused by P. malariae. Take note of the absence of any dotted features. A key feature in a P. malariae infection is the absence of dots.
#24.
Species Identification ③ Dots Are dots visible in the following specimens? Dotted features can be clearly seen within the infected RBCs. These are known as Schuffner's dots. These features can also be seen in the schizont stage. Top: P. vivax Bottom: P. ovale
#25.
Species Identification ③ Dots Are dots visible in the following specimen? This is an infection caused by P. falciparum. The dots are relatively larger but lower in count. These are called Maurer's dots (cleft). They are characteristic of P. falciparum.
生殖細胞とその識別方法
#26.
Species Identification ③ Dots Caution: Dots are relatively few in the ring form stage. They are best seen in the growing trophozoite and beyond.
#27.
Species Identification ③ Dots Are dots visible in the following specimen? This is the ring form (early trophozoite) stage. Dots are difficult to evaluate at this stage.
#28.
Species Identification ④ Gametocyte Gametocytes appear later in comparison to the trophozoites. They may not always be present in an infection. Gametocytes can either be male (microgametocyte) or female(macrogametocyte). Take note that sexual reproduction only takes place in the mosquito. Male and female gametocytes that are found in humans remain similar in size. However, within the mosquito, the male divides into 8 small flagellated bodies where they enter the larger female gametocyte. For this reason, they are named microgametocyte and macrogametocyte respectively.
#29.
This is the gametocyte of P. falciparum. The banana-shape is characteristic of P. falciparum. Take note of the brown granules in the central portion of the cell. They are known as malarial pigment and is thought to be responsible for iron metabolism. On the right is a microgametocyte (male). Its characteristic features include a deep pink color and rounded ends. These features are only relevant for research purposes. Species Identification ④ Gametocyte
#30.
Species Identification ④ Gametocyte Excluding P. falciparum, the gametocytes of other species have a round shape. The chromatin (nucleus) can be seen at the periphery of the macrogametocyte. However, it may be more difficult to identify the chromatin in the microgametocyte. Other features that were described previously (size/shape of infected RBCs, dots) are also applicable in this stage.
P. falciparumの診断的特徴
#31.
Species Identification ④ Gametocyte This is the gametocyte of P. vivax. Take note of the larger size of the infected RBC. Schuffner’s dots can also be seen. Top: macrogametocyte Bottom: microgametocyte
#32.
Species Identification ④ Gametocyte This is the gametocyte of P. ovale. Take note of the irregular shape of the infected RBC and the presence of Schuffner's dots. Caution: This irregular (elliptical) shape of infected RBCs is also seen in P. vivax infections.
#33.
Species IdentificationP. falciparum
#34.
Species Identification P. falciparumKey Diagnostic Findings: We see a number of parasites in the ring form. The cellular component of the parasite is scant. This is a characteristic finding of a P. falciparum infection. Infected RBCs are the same size as other RBCs. We can see 2 ● within the ring form. It is called the double chromatin and is a sign of active replication.
#35.
Species Identification P. falciparumKey Diagnostic Findings: Early~Growing Trophozoite In comparison to the ring form, the parasitic cellular component is denser and the vacuole is smaller in size. Maurer‘s dots can also be seen. These findings suggest an infection caused by P. falciparum.
P. vivaxおよびP. ovaleの識別技術
#36.
1) Synchronization of the Stage of Infection In some cases of P. falciparum infection, every infected RBC may exhibit the same parasitic lifecycle stage. (i.e. only ring forms can been seen) The cycle of the infective stages of P. falciparum is around 48 hours. The parasites enters the RBC, matures, and exits the RBC in a synchronized fashion. Species Identification P. falciparumKey Diagnostic Findings:
#37.
Species Identification P. falciparumKey Diagnostic Findings: 2) Sequestration Knobs are expressed on the surface of infected RBCs that contain maturing trophozoites. These knobs cause infected cells to adhere to blood vessel walls. This process is called sequestration. This critical virulence factor of P. falciparum leads to organ hypoperfusion. This is the reason why stages beyond the growing trophozoite is not commonly seen in a P. falciparum infection. Once infected RBCs adhere to the vessel wall, they remain sequestered until the merozoites burst out of the infected cells. With synchronization and sequestration in mind, we can identify a P. falciparum infection if a significant number of ring forms is detected without other stages in the blood smear.
#38.
Double chromatin and Double infection Double Infection occurs when 2 or more types of species infect a single RBC. Double chromatin is seen when 2 nuclei are present for 1 parasitic cellular component. It is a sign of active replication. Both findings are commonly seen in P. falciparum infections.
#39.
P. falciparum Schizont This is the schizont of P. falciparum and is a rare finding. A high merozoite count is detected. Take note of the normal size of the infected RBC.
#40.
P. falciparum Gametocyte This is the gametocyte of P. falciparum. Note the characteristic banana shape. On the right is a microgametocyte (male). Its characteristic features include a deep pink color and rounded ends. These features are only relevant for research purposes.
マラリアの種識別の総括とクイズ
#41.
Species Identification P. falciparumSummary: 1)Normal size of the infected RBC2)Only ring forms are seen3)Maurer’s dot (Early~Growing trophozoite)4)Banana-shape gametocytes5)High merozoite count <average 16> (Schizont stage)
#42.
Species Identification P. vivax
#43.
Species Identification P. vivaxThe Technique: The infected RBC is relatively larger than the surrounding RBCs. Schuffner’s dots are present within the RBC. This is the growing trophozoite stage of P. vivax. Parasitic cellular components are disordered, enlarged, and shaped like an amoeba. Known as the amoeboid form, it is a defining characteristic of P. vivax.
#44.
Species Identification P. vivaxThe Technique: This is the late trophozoite stage of P. vivax in the amoeboid form. The cellular components have increased in size and density. The infected RBC is relatively larger than the surrounding cells. Schuffner's dots can also be seen within the RBC.
#45.
Species Identification P. vivaxThe Technique: Schizont stage Multiple merozoites can be seen within the RBC. Take note of the elliptical shape and relative large size of the infected RBC. P. vivax can be identified by its high merozoite count.
#46.
Species Identification P. vivaxThe Technique: This is the gametocyte (macrogametocyte). The infected RBC is relatively larger than the surrounding cells. Schuffner's dots are also visible.
#47.
Species Identification P. vivaxThe Technique: 1)Large size of the infected RBC 2)Shuffner’s dot 3)Amoeboid form (Early ~Late trophozoite) 4)High merozoite count <average 16> (Schizont stage)
#48.
Species IdentificationP. ovale
#49.
Species Identification P. ovaleThe Technique: As the name “ovale” suggests, infected RBCs take on a characteristic oval shape. However, the shape may not always be symmetrical. It may also exhibit a teardrop shape with one side having a jagged, pointed edge. This is the growing trophozoite of P. ovale. Schuffner's dots can be seen within the RBC.
#50.
Species Identification P. ovaleThe Technique: This is the schizont. 8 merozoites can be seen within the infected RBC. Up to 12 merozoites can be seen in with a RBC infected with P. vivax. The merozoite count is a key element in the process of species identification. Schuffner's dots can also be seen.
#51.
Species Identification P. ovaleThe Technique: This is the gametocyte of P. ovale. As the chromatin is not clearly visible, the specimen is a microgametocyte. Schuffner’s dots can also be seen. The brown-colored components are malarial pigments.
#52.
Species Identification P. ovaleSummary: 1)Irregular (elliptical) shape of the infected RBC 2)Schuffner’s dots 3)Merozoite count: 6-12 <average 8>
#53.
Species IdentificationP. malariae
#54.
This the growing trophozoite of P. malariae. Take note of the normal size of the infected RBC. The absence of dots is the characteristic finding. Species Identification P. malariaeThe Technique:
#55.
This is the growing trophozoite. The band form is characteristic of a P. malariae (and P. knowlesi) infection. Note that the band form may not always be present in the blood smear. Although it may be tempting to rely solely on this finding to identify P. malariae, it is more prudent to consider this finding as a fortunate, incidental one. It is recommended to utilize the other techniques described in the presentation rather than depending on this finding. Species Identification P. malariaeThe Technique:
#56.
This is a schizont of P. malariae. At the center are merozoites (6-12, on average 8) which are surrounded by brown pigment. The characteristic rosette formation can be seen. It is important to note that this formation is not always clearly visible like the specimen on the left. Species Identification P. malariaeThe Technique:
#57.
This is the gametocyte of P. malariae. It can be identified as a macrogametocyte from the presence of chromatin. Note the relative normal size of the infected RBC and the absence of dots. Brown malarial pigments can also be seen. Species Identification P. malariaeThe Technique:
#58.
Species Identification P. malariaeSummary: 1)Normal size of the infected RBC2)Absence of dots 3)Band form → Growing trophozoite4)Rosette formation → Schizont 5)Merozoite count: 6-12 <average 8>
#59.